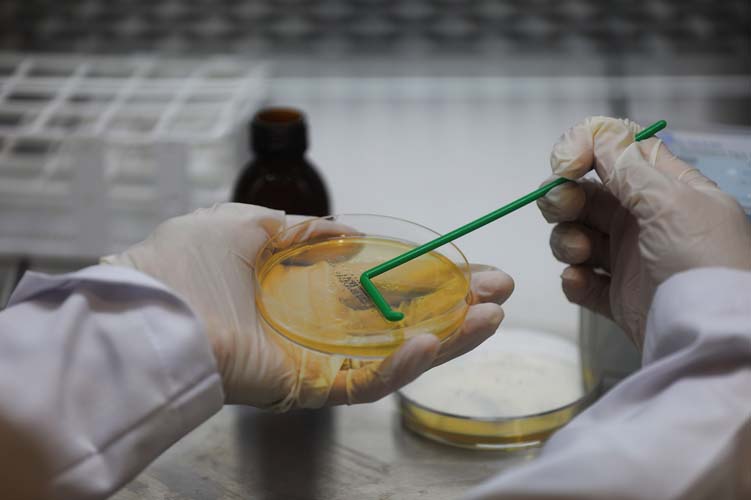
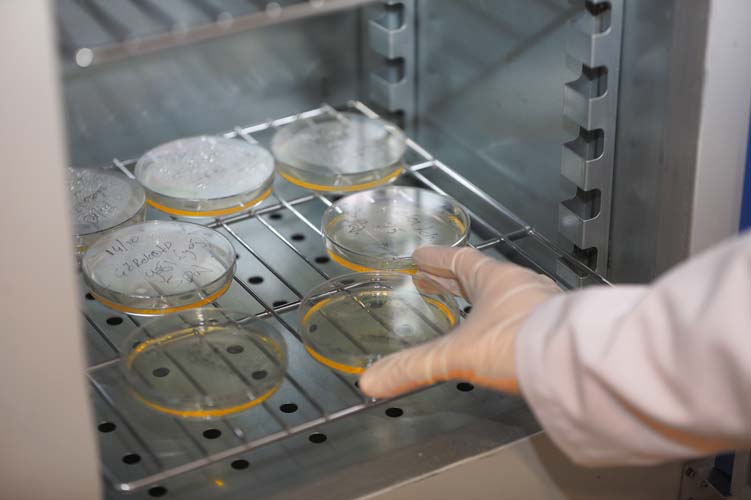

Türkiye’nin en büyük tarımsal üretim projelerinden birine imza atarak Melen Botanik Vadisi’nde ürün eken, işleyen ve pazara kazandıran Büyükşehir Belediyesi, Sakarya için her geçen gün katma değer üretmeye devam ediyor.
Tarımsal üretimin ve güçlü bir bağışıklığın son derece önemli olduğunu tüm dünyanın fark ettiği pandemi sürecinde, bir tarım cenneti haline dönüştürülen arazilerde üretime başlayan ve şifa evlerini şehre kazandıran Büyükşehir, şifalı tıbbi ve aromatik bitkilerden üretilen 93 kalem ürünü yerel marketler ve e-ticaret platformlarında çok kısa bir sürede şifalı ürünlerini vitrine çıkardı.
Büyükşehir işleyip vitrine koyuyor
Sakarya Büyükşehir Belediyesi 60 kilometrelik Melen Botanik Vadisi’nde yüzlerce çeşit aromatik bitkinin üretimine başladı. İlk günden bu yana büyük ilgi gören ürünlerin %90’ı ilk etapta talep üzerine yurt dışına ihraç edildi.
Bu şekilde oluşturulan ticaret hacmiyle üretim sahasını genişleten Büyükşehir, ürünlerin %10’luk kısmını ise her aşamasıyla birlikte kendisi işlemeye başladı. Hipokrat’ın ‘Besinler ilacınız, ilacınız besininiz olsun’ sözünün önemine işaret eden bir anlayışla yola çıkan Büyükşehir, kısa bir süre sonra Ali Taner Tıbbi ve Aromatik Bitki Laboratuvarı’nı kurdu.
Aromatik, tıbbi bitkiler şifaya dönüşüyor
Sakarya’da oluşturulan tarım cenneti arazilerde verimli topraklardan alınan yüzlerce çeşit tıbbi ve aromatik bitkinin şifaya dönüşme serüveni ise bu laboratuvarda başladı. Kurulan özel ekip bu ürünleri büyük bir özenle işleyerek yağ, hidrosol, çay, sabun, kolonya, krem, mum ve losyona dönüştürdü.
Yerel üreticiye destek olan, sözleşmeli tarım modelini benimseyen ve vatandaşlara her biri şifa olan ürünleri kolay şekilde ulaştıran bu sistem büyük ilgi gördü. Belediye, kendi üretimi ile çiftçiden temin ettiği tüm ürünlerle, Sağlık Bakanlığı onaylı formüllerle 93 kalem ürüne dönüştürdü. Bu üretim merkezi araştırma ve ürün geliştirme çalışmalarının yanı sıra gıda, kozmetik ürünlerinin de mikrobiyolojik analizlerinin yapılmasıyla Türkiye’de öncü bir model oldu.
Bakanlık onaylı, sertifikalı ürünler
Doğal tedavi, alternatif tıp ve geleneksel doğal ürünler alanında dünyanın örnek aldığı sistem Sakarya için şifa kaynağı oldu. Tüm ürünler ISO 90001, ISO 22000 ve Helal Gıda Sertifikası’nı aldı. Sakarya genelinde hizmete açılan şifa evleri, internet ortamlarında oluşturulan satış sistemleri ve ihracat yoluyla ulaştırılan ürünler yoğun bir talep gördü.
1 yılda elde edilen 222 bin adet ürünün büyük kısmı e-ticaret sitelerinde kısa sürede satıldı. Satış uygulamalarında alışveriş yapan müşterilerin puanlamasıyla Sera A.Ş 5 puan üzerinden 4.8 puan aldı. En çok satılan ürünler arasında ise kenevir tohumu yağı, çörekotu yağı, kantaron yağı, susam yağı, badem yağı ile ınvıctus, limon, nehir ada, lavanta kolonyaları, altın, güneş koruyucu kremleri, hep-mis parfümü, lavanta hidrosolü, kenevir tohumu yağlı, zeytin yağlı, bal ile polenli sabunlar yer aldı.
Doğal şifaya talep yüksek
Bu ürünler daha çok cilt sağlığını koruyucu özellikleri sebebiyle tercih ediliyor. Üretilen yağlar ise ‘inhaler’ yöntemiyle buhurdanlık kullanılarak solunum yolunu rahatlatıcı özelliğiyle ön plana çıkıyor. Bitki özlerinden üretilen doğal kremler ve sabunlar ise saç, cilt ve vücut bakımında %100 doğal olduğu için tercih ediliyor. Üretilen parfümler ve hidrosoller ise yine tamamen doğal bir ‘aromaterapi’ imkanı sunuyor.
Koku, parfüm oil ürünleri de uçucu şekilde değerlendirilerek rahat bir uyku, berrak bir zihin oluşmasında doğal bir etki oluşturuyor. Petrol ve türevleri içermeyen mumlar ise doğallığıyla dikkat çeken ürünler arasında yer alıyor. Kadınlar ise özellikle doğal güneş kremi, losyon, sabunlar ve hidrosolleri cilt bariyerini onarıcı ve doğal nemlendirici özellikleri sebebiyle tercih ediyor.
Doğal şifalı ürünleri halka sunuyoruz
Sera A.Ş.’den yapılan açıklamada, “Sakarya Büyükşehir Belediye Başkanı Sayın Ekrem Yüce önderliğinde kurulan Ali Taner Tıbbi ve Aromatik Bitki Laboratuvarı’nda misyonumuz; doğal ve şifalı ürün teminini artırmaktır. Doğallığına emin olduğumuz kendi bünyemizde yetiştirdiğimiz aromatik bitkilerden ürettiğimiz doğal ürünleri vatandaşımızın faydalanması için uygun fiyata ulaştırıyoruz. Aromatik bitkilerin buharlı distilasyon ve soğuk sıkım yolu ile sabit ve uçucu yağlara dönüşmesini sağlıyoruz. Büyükşehir artık bu çatı altında tamamen güvenli ve bakanlık onaylı ürünler üretiyor, doğal ürünleri şifaya dönüştürüyor. Talep arttıkça, kapasitemizi de inşallah artıracağız” denildi.